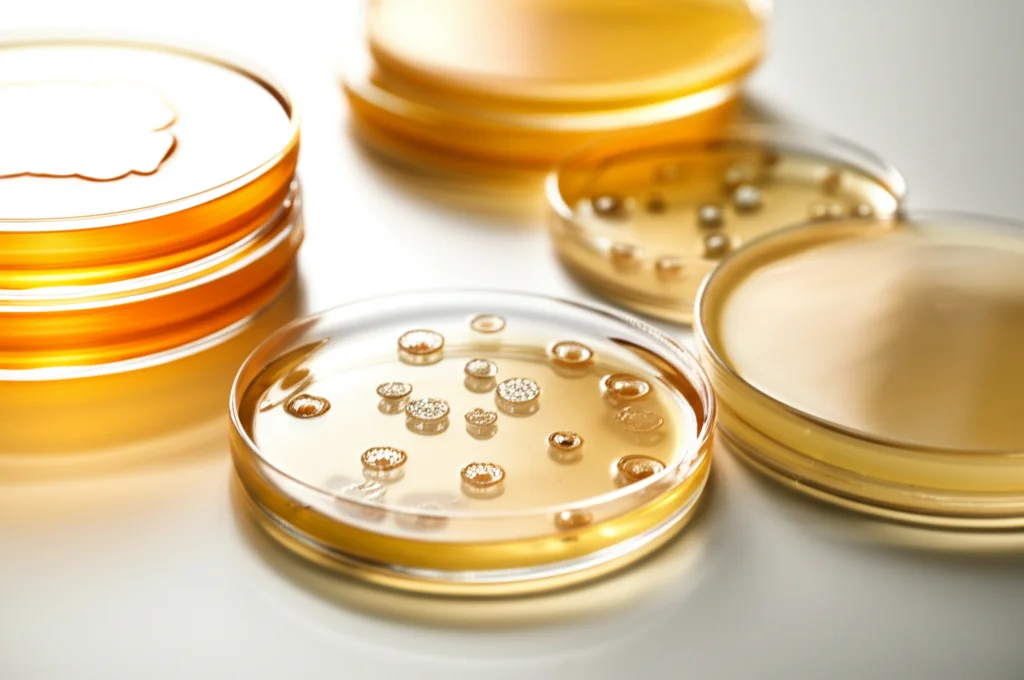
Still life in laboratorio, lente macro 100mm, che mostra diverse piastre Petri con gel di agar. Alcune piastre mostrano crescita batterica evidente, mentre altre hanno pozzetti riempiti con un olio essenziale trasparente senza alcuna zona di inibizione visibile attorno. Alta definizione, messa a fuoco precisa, illuminazione controllata da laboratorio.

Linfa di Pino Caraibico: Un Tesoro Nascosto con un Potenziale Antimicrobiano Inatteso?
Ciao a tutti! Oggi voglio parlarvi di qualcosa che mi ha davvero incuriosito ultimamente. Siamo stati tutti bombardati, specialmente negli ultimi anni con la pandemia di COVID-19, dall’uso quasi ossessivo di igienizzanti per le mani. Comodi, certo, soprattutto quando acqua e sapone non sono a portata di mano. Ma ci siamo mai fermati a pensare a cosa c’è dentro quella roba chimica che ci spalmiamo addosso così spesso?
Il Lato Oscuro degli Igienizzanti Comuni
La verità è che molti igienizzanti commerciali sono pieni zeppi di fragranze sintetiche e additivi chimici che, diciamocelo, non fanno proprio benissimo né a noi né all’ambiente. Avete mai sentito parlare del triclosan? Beh, è uno di quegli ingredienti sotto accusa, collegato a problemi come interferenze endocrine, allergie, resistenza antimicrobica e persino rischi di cancerogenesi. Senza contare l’alcool, spesso presente in grandi quantità: secca la pelle, può causare irritazioni, prurito, screpolature e, nei casi peggiori, se ingerito (sì, succede!), può portare a intossicazioni serie, come purtroppo è accaduto in alcune parti del mondo. E non dimentichiamo l’impatto sull’ambiente e sulla biodiversità quando tutte queste sostanze finiscono disperse. Insomma, un quadro non proprio idilliaco.
Alla Ricerca di Alternative Naturali: Occhi Puntati sul Pino
Di fronte a queste preoccupazioni, è naturale che la ricerca si stia muovendo verso alternative più “verdi”. E qui entra in gioco il protagonista della nostra storia: il Pinus caribaea var. hondurensis, una varietà di pino caraibico molto diffusa nelle zone tropicali, compresa l’Africa. Questo albero resinoso è già noto per essere una fonte di oli essenziali ricchi di composti interessanti, ma finora ci si era concentrati soprattutto su aghi e fusti. E la linfa? Pochi l’avevano presa in considerazione seriamente. Eppure, vista l’abbondanza di questa pianta, poteva rappresentare una risorsa nuova e non sfruttata per sviluppare formulazioni antimicrobiche naturali.
Ed è proprio qui che si inserisce uno studio affascinante condotto in Uganda. L’obiettivo? Capire cosa c’è dentro la linfa di questo pino e, soprattutto, estrarne l’olio essenziale per valutarne le componenti bioattive e il potenziale antibatterico. Poteva essere la base per un nuovo igienizzante naturale, efficace e sicuro? L’idea era decisamente intrigante!
Cosa Nasconde la Linfa: L’Analisi Fitochimica
Il primo passo è stato “interrogare” la linfa. Attraverso analisi qualitative, i ricercatori hanno cercato la presenza di diverse classi di composti fitochimici. I risultati?
- Presenti: Flavonoidi e Alcaloidi. Buone notizie, perché sono composti spesso associati a proprietà benefiche!
- Assenti: Tannini, Antrachinoni e Saponine. È interessante notare che i tannini, ad esempio, erano stati trovati negli aghi dello stesso pino in studi precedenti. Questo ci dice che la parte della pianta da cui si estrae l’olio fa una bella differenza!
Questi primi risultati confermavano la presenza di molecole potenzialmente interessanti.

Distillando l’Essenza: L’Olio Essenziale
Il passo successivo è stato estrarre l’olio essenziale vero e proprio dalla linfa. Come? Con un metodo classico e affascinante: l’idrodistillazione. Immaginate un processo simile a quello per fare la grappa o altri distillati: la linfa viene mescolata con acqua e riscaldata. Il vapore che si forma porta con sé le molecole aromatiche e volatili dell’olio essenziale. Questo vapore viene poi raffreddato, tornando liquido, e l’olio, che non si mescola con l’acqua, viene separato. Da 500 grammi di linfa, dopo 3 ore di distillazione, si ottiene questo prezioso concentrato.
Dentro l’Olio: La Carta d’Identità Chimica (GC-MS)
Una volta ottenuto l’olio, la domanda cruciale era: cosa c’è dentro esattamente? Per scoprirlo, è stata usata una tecnica potentissima chiamata Gas Cromatografia-Spettrometria di Massa (GC-MS). È come dare una carta d’identità a ogni molecola presente nell’olio. E i risultati sono stati sorprendenti! Sono stati identificati ben 23 composti bioattivi. I pezzi da novanta erano:
- Sabinene: ben il 34.24%! È il componente dominante.
- β-Pinene: con il 24.82%, un altro classico dei pini.
- α-Thujene: all’11.5%.
Accanto a questi “big”, c’erano molti altri composti in quantità minori, come Anetolo, Linalolo, Acetato di Isolongifololo, Canfene, Ciclopentene, γ-Terpinene, Fencholo, allo-Ocimene, Isopulegolo, Levomentolo, Borneolo, Citronellolo, α-Longipinene e Cariofillene.
Questo profilo chimico è risultato diverso da quello trovato in oli essenziali estratti dagli aghi di *P. caribaea* in studi precedenti, dove dominavano limonene e α-pinene. Ancora una volta, la fonte (linfa vs aghi) cambia le carte in tavola!
Potenzialità sulla Carta: Cosa Dicono i Componenti?
Guardando i componenti principali, le aspettative erano alte. Il Sabinene è noto per le sue proprietà anti-infiammatorie, antimicrobiche e antiossidanti. Il β-Pinene è studiato per le sue capacità antibatteriche e antifungine, potenzialmente utile per prodotti per la cura delle ferite o l’igiene personale. Anche l’α-Thujene mostra attività antibatterica. Persino alcuni composti minori come Canfene e Borneolo hanno attività antimicrobica e anti-infiammatoria. Insomma, un cocktail di molecole che sulla carta prometteva bene per un’azione contro i batteri!
La Prova del Nove: L’Olio Essenziale Contro i Batteri
Era il momento della verità: l’olio essenziale estratto dalla linfa di *P. caribaea* sarebbe stato in grado di fermare la crescita dei batteri? Per scoprirlo, i ricercatori hanno messo alla prova l’olio contro sei ceppi batterici “tosti”, responsabili di molte infezioni comuni:
- Escherichia coli (due ceppi, uno “selvaggio” e uno standard ATCC)
- Staphylococcus aureus (due ceppi, uno “selvaggio” e uno standard ATCC)
- Pseudomonas aeruginosa (due ceppi, uno “selvaggio” e uno standard ATCC)
Il metodo usato è stato quello della diffusione su agar. In pratica, si “semina” il batterio su una piastra con un terreno di coltura gelatinoso (l’agar) e poi si crea un piccolo pozzetto in cui si mette l’olio essenziale. Se l’olio è efficace, intorno al pozzetto si forma un alone trasparente, detto “zona di inibizione”, dove i batteri non riescono a crescere. Per confronto, sono stati testati anche oli essenziali di limone e cedro, spesso usati in igienizzanti naturali.
Il Risultato Inatteso: Nessuna Inibizione!
E qui arriva la sorpresa, forse un po’ deludente: l’olio essenziale di linfa di *Pinus caribaea*, alle condizioni testate, non ha mostrato alcuna attività inibitoria contro nessuno dei sei ceppi batterici. Zero zone di inibizione. Nada.
Questo risultato sembra contraddire le potenzialità suggerite dai singoli componenti come Sabinene e β-Pinene. Come mai? Le ragioni possono essere diverse. Forse la concentrazione dei singoli composti attivi nell’olio totale non era sufficiente. Forse l’interazione tra i vari componenti dell’olio annulla l’effetto antimicrobiano (a volte succede!). O forse, semplicemente, questi specifici batteri sono particolarmente resistenti a questo specifico mix di molecole. È interessante notare che anche studi precedenti su altre specie di *Pinus* avevano mostrato un’attività antimicrobica limitata o assente contro alcuni batteri, come *E. coli*.
Non Tutto è Perduto: Prospettive Future
Quindi, dobbiamo buttare via tutto e dire che la linfa di pino è inutile? Assolutamente no! Questo studio è un primo passo importante. Anche se non ha mostrato un’azione antibatterica diretta *in questo specifico test*, ha rivelato una composizione chimica unica e ricca di molecole interessanti (Sabinene, β-Pinene, α-Thujene in primis).
Questi composti hanno altre proprietà note (anti-infiammatorie, antiossidanti) che potrebbero essere sfruttate nell’industria cosmetica e farmaceutica. Pensiamo a prodotti per la cura della pelle, per lenire irritazioni, o magari in combinazione con altri ingredienti per potenziare formulazioni naturali.
La conclusione dello studio è chiara: servono ulteriori ricerche. Bisogna esplorare diverse concentrazioni dell’olio, provare metodi di estrazione differenti, testarlo in combinazione con altre sostanze e magari contro un pannello più ampio di microrganismi (funghi, altri batteri). La strada per un igienizzante a base di linfa di pino è forse più lunga del previsto, ma il potenziale di questa risorsa naturale rimane tutto da scoprire. È un promemoria che la natura è complessa e non sempre ci dà le risposte che ci aspettiamo al primo tentativo, ma vale sempre la pena continuare a indagare!
Fonte: Springer
